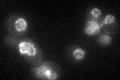
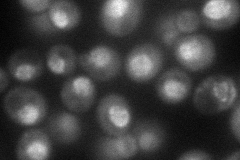
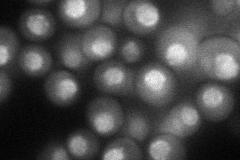

View description
Essential structural subunit of the nuclear pore complex (NPC), localizes to the nuclear periphery of nuclear pores, homologous to human p205
Localization:
Intensity:
Fold change:
Significance:
-
C’ GFP library in SD
nuclear periphery38.15 -
N' NOP1pr-GFP in SD
punctate,nucleus104.831 -
N' TEF2pr-mCherry in SD
punctate,nuclear periphery54.443 -
N' NATIVEpr-GFP in SD

punctate,nuclear periphery51.585 -
N' TEF2pr-VC and Cyto-VN in SD

punctate,nuclear periphery43.7123 -
C’ GFP library in SD+DTT

nuclear periphery37.450.98No -
C’ GFP library in SD+H2O2

nuclear periphery36.030.94No -
C’ GFP library in Starvation Media

nuclear periphery45.521.19No -
C’ GFP library on the background of Pup2-DaMP

N/A -
C’ GFP library on the background of CCT mutant

N/A0N/AYes
